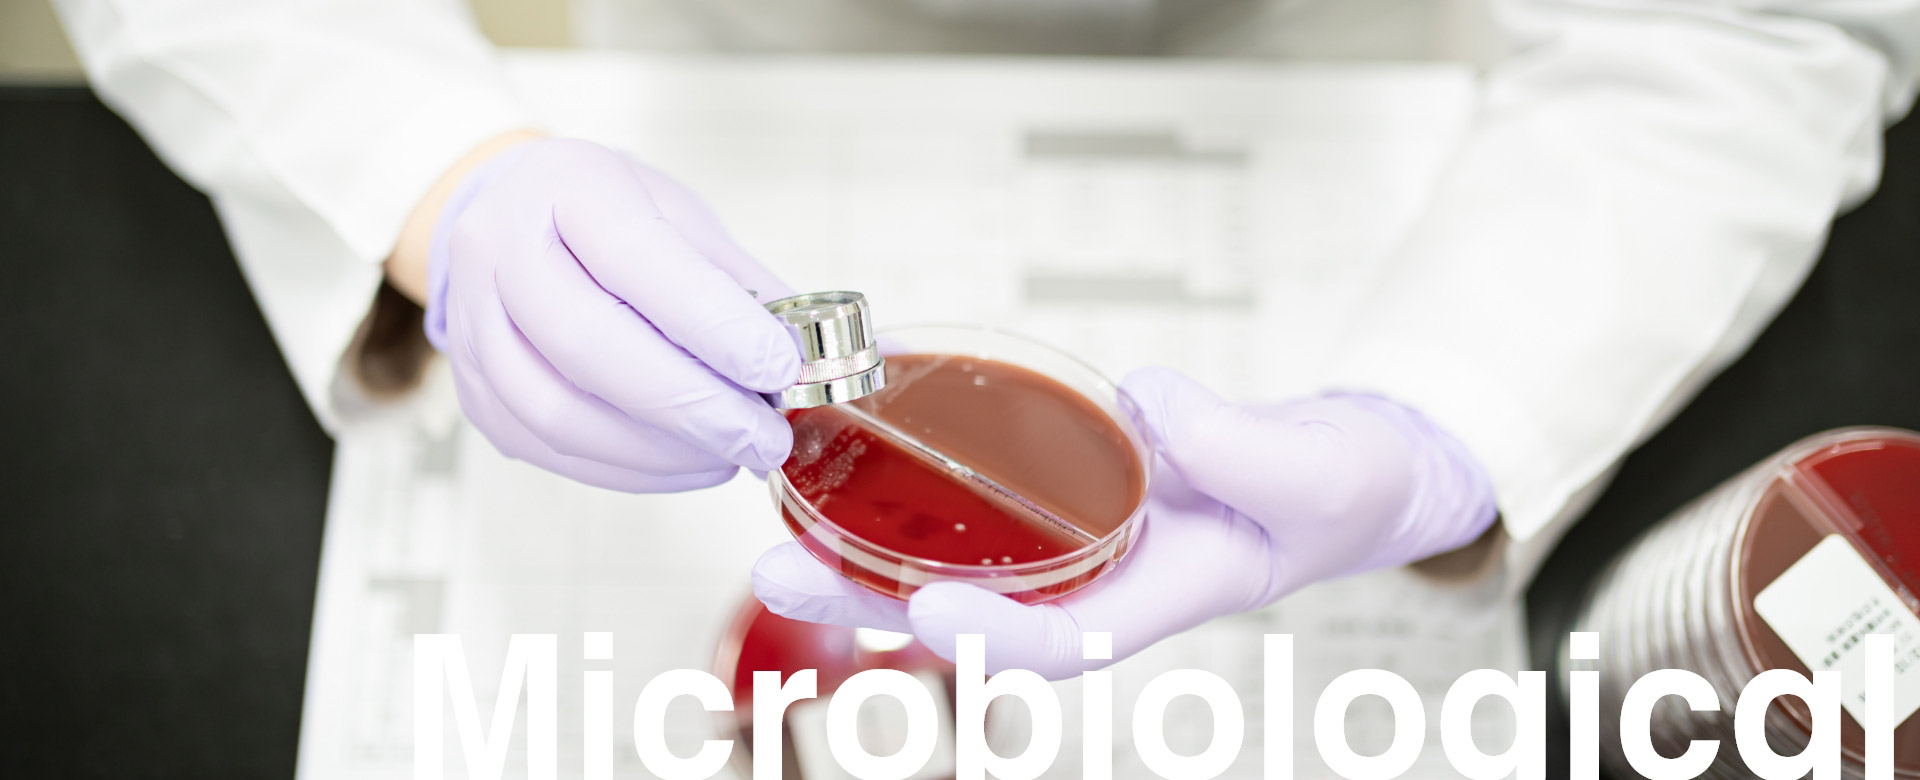

検査のご依頼から検査結果の報告まで
検査のご依頼
細菌専用依頼書をこちらからお持ちして、検査の依頼内容を詳しくご記入していただきます。
(塗沫、培養、感受性、嫌気性培養など)
検査開始
まず始めに細菌が存在するかどうかを判断します。所要日数は検体をお預かりしてから約1日程度です。
(一部の細菌は除きます)
菌名の判定
菌名まで判定が終わりましたら、次にその細菌に対してどの薬剤が効果的なのかを判定します。
薬剤感受性の判定には検体をお預かりしてから約3~4日かかります。
検査結果の報告
検査報告書は通常の報告書の他に集団用(健診用)も用意しています。
事前にご連絡いただければ報告書の二部出しなども対応いたします。
至急でお預かりした場合は、出次第FAX又は口頭報告にてご連絡いたします。













